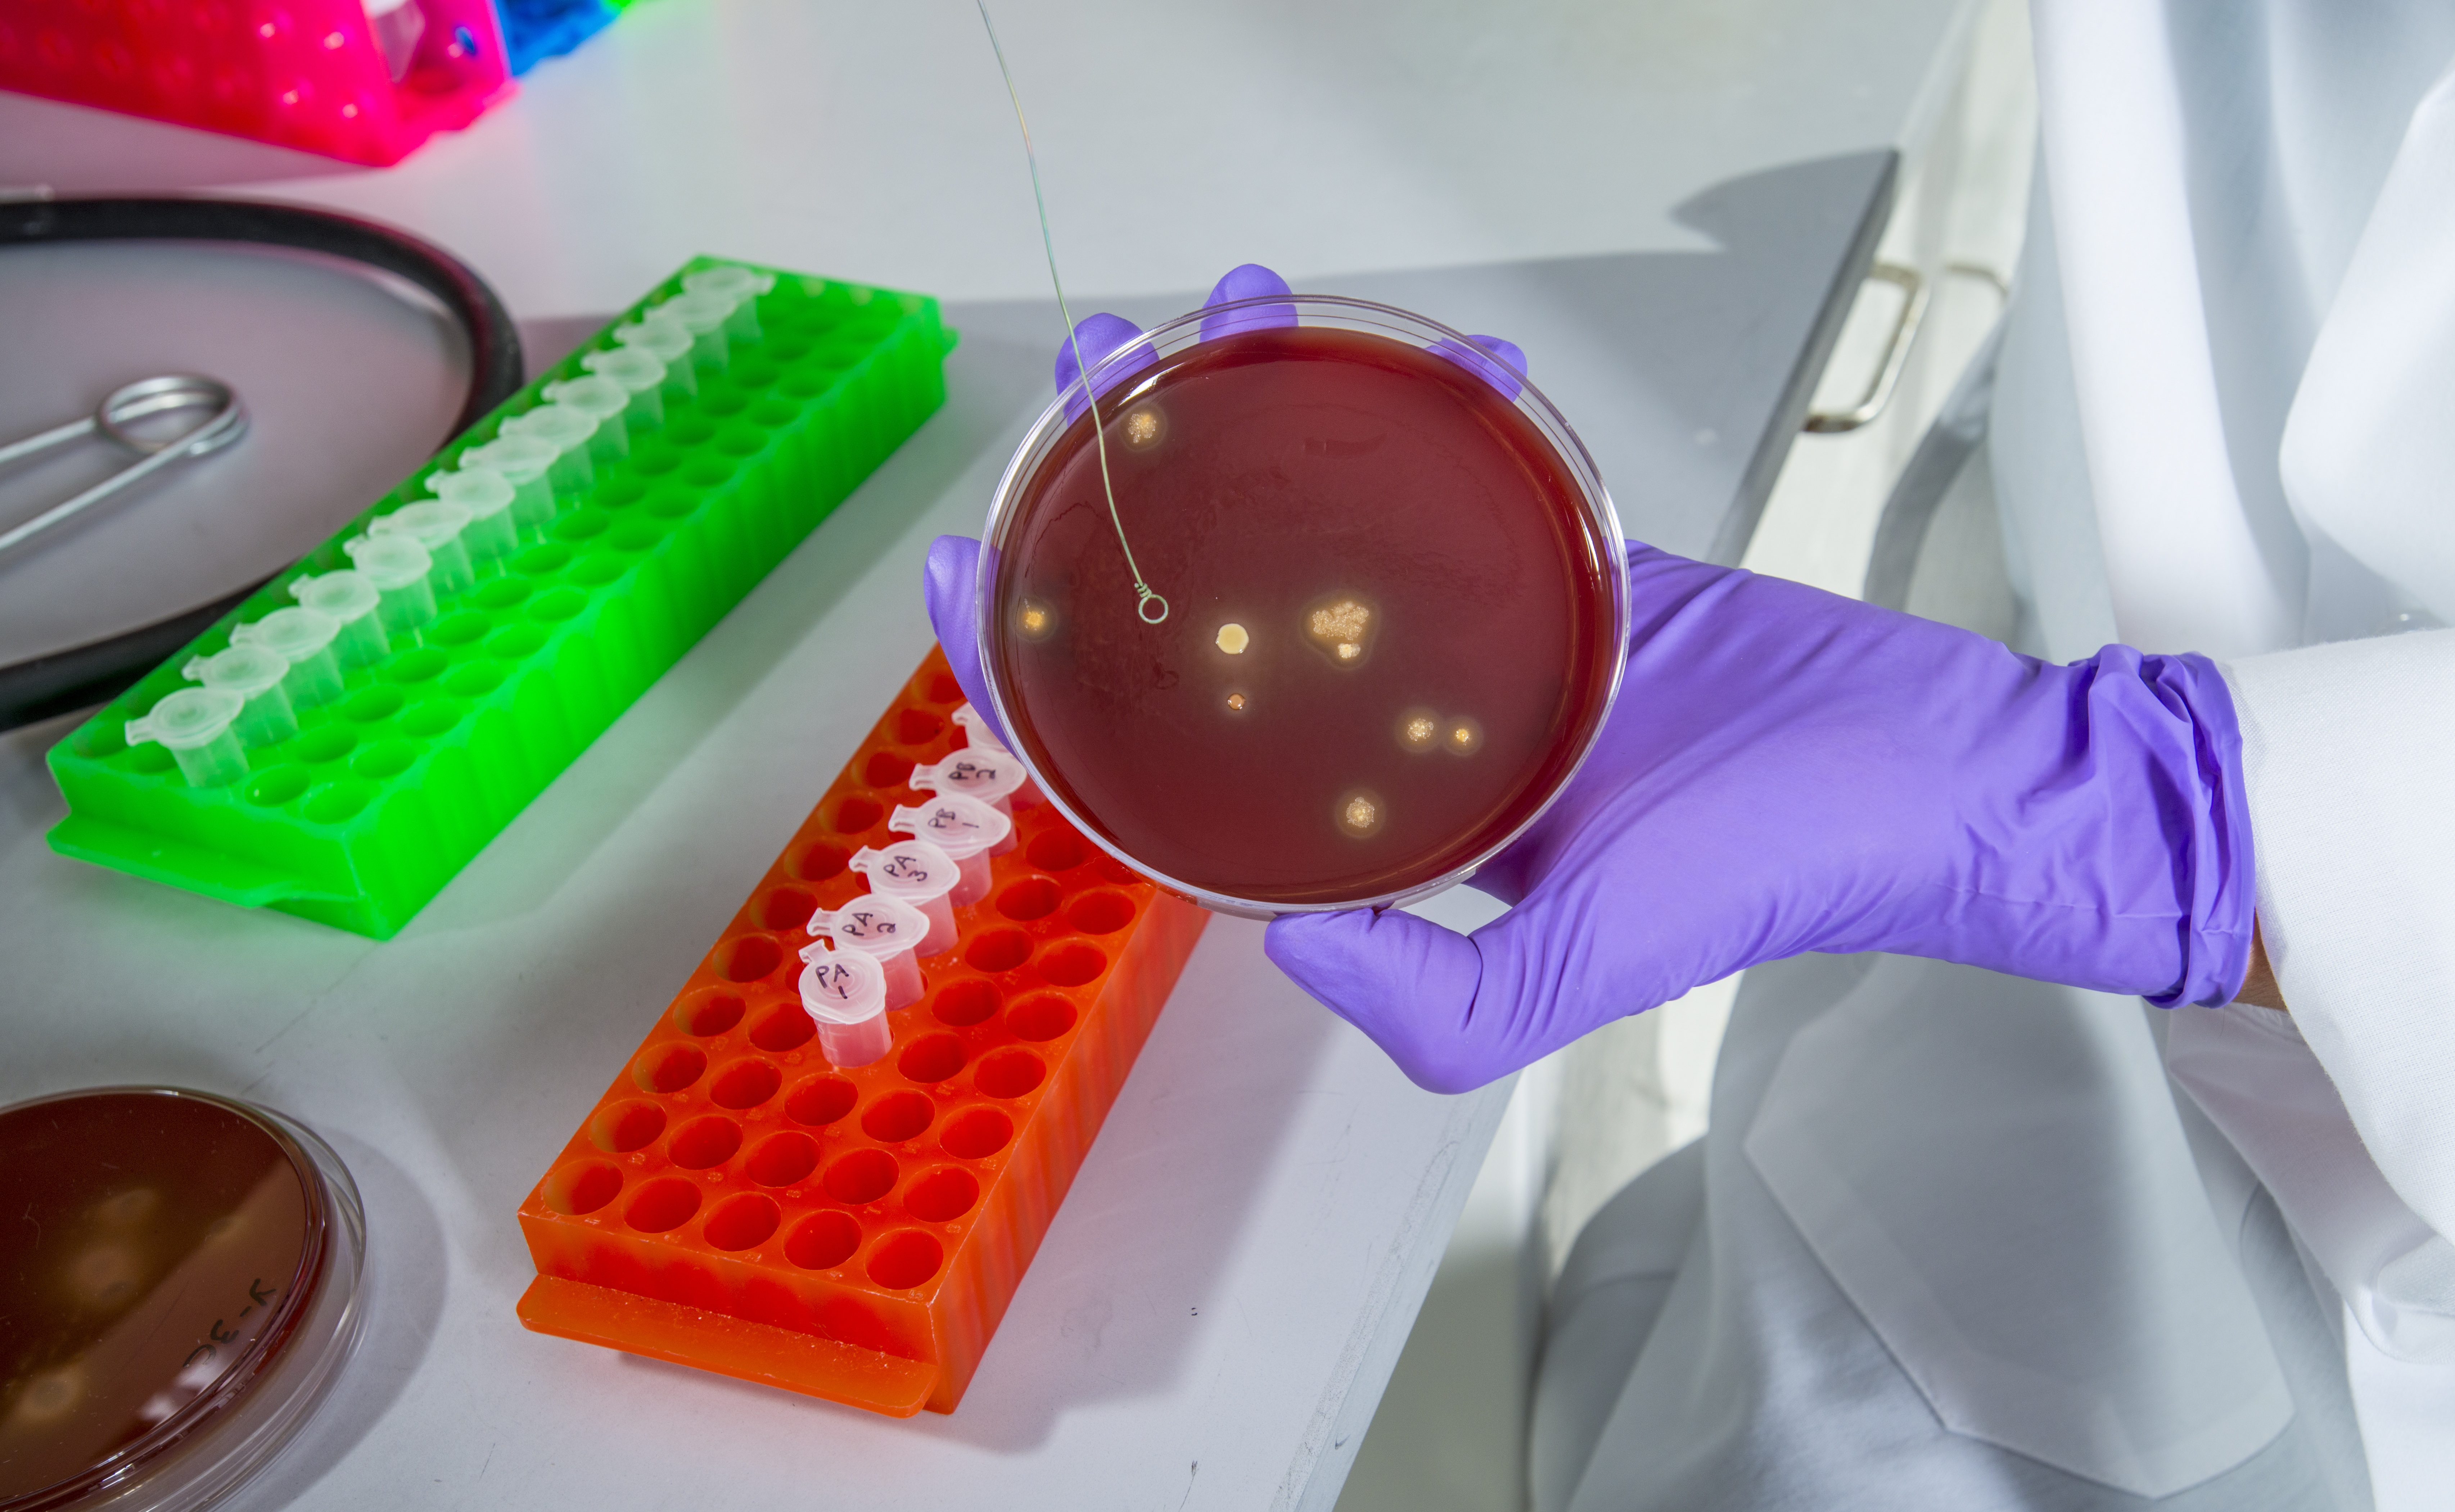
Dental Bib Clip Bacteria

Möchten Sie immer auf dem neuesten Stand bleiben?
Erstellen Sie noch heute ein Leserkonto, um die Branchen und Unternehmen zu verfolgen, die Sie interessieren, und passen Sie Ihr Nachrichten-Dashboard an.
-
Oxnard, Calif., Aug. 28, 2013 (GLOBE NEWSWIRE) -- A recent report authored by John A. Molinari, Ph.D. and Peri Nelson, B.S., and made available today courtesy of DUX Dental, suggests that there are...
-

Oxnard, Calif., Aug. 6, 2013 (GLOBE NEWSWIRE) -- It's on! The search for the ugliest dental bib clip in America, that is. Low-down dirty characters like "Rusty Chain", "Bite Midler", "Clip Cardashian"...
-

OXNARD, Calif., Dec. 17, 2012 (GLOBE NEWSWIRE) -- In support of the upcoming National Children's Dental Health Month and "Give Kids a Smile®" day on Feb. 1, 2013, DUX Dental has donated 575 boxes...
-

OXNARD, Calif., April 23, 2012 (GLOBE NEWSWIRE) -- DUX Dental will kick-off its fourth-annual "Bib-Eze™ for Boob-Eze" campaign to benefit the American Breast Cancer Foundation (ABCF) next week...
-

OXNARD, Calif., March 19, 2012 (GLOBE NEWSWIRE) -- This week, researchers at the University of Witten/Herdecke in North Rhine-Westphalia, Germany released a clinical study indicating that the...